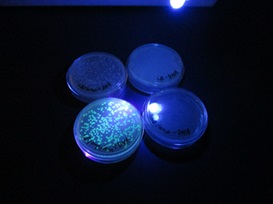

![]() |
![]() |
課研:コラボレーションラボ~リサーチⅠ発表会~
2月25日(水)
テーマ設定の過程でまとめた研究計画を2年次生理数科の生徒に向けて発表しました。1年次生の研究班1班あたり2年次生の研究班4班に順に聞いてもらい、アドバイスをもらいました。
自分たちの研究計画に足りないことを認識し、新たな視点に気づくことができ、大変有意義な活動となりました。
今回のアドバイスを基に春季休業中に研究計画を改善し、新年度を迎えます。
![]() |
![]() |
課研:サイエンス・ダイアログ~見学~
2月3日(火)
日本の大学や研究機関で活躍されている若手外国人研究者3名による講演会を実施し、専門の研究や母国について語っていただきました。
前半は2年次生の22の研究班が英語でプレゼンテーションを行う様子を見学しました。後半は3分野に分かれて2年次生の生徒とともにオールイングリッシュでの講義を受けました。1年後の活動を意識することができました。
![]() |
![]() |
課研:冬季休業課題 発表会
1月9日(金)
冬季休業の課題「テーマ設定トライアル2」の発表会を行いました。
問いをテーマ化し、これを検証するための仮説と実験計画を考え、客観的な根拠に基づく仮説を立て、知りたいことを明らかにできる実験を考え、レポートにまとめました。
発表・質疑応答の後、ルーブリックによる相互評価も行いました。
![]() |
![]() |
SSR:生命科学セミナーⅡ~光る大腸菌~
12月3日(水)~5日(金)
SSH事業の一環として理数生物の授業で本校生物科教諭による「光る大腸菌」の実験を実施しました。
大腸菌の遺伝子組換えを行い、紫外線で光る大腸菌をつくりました。
遺伝子組換え操作を通して、生命科学分野での先端科学技術を体験し、学習意欲の向上を図り、遺伝子と遺伝子工学の可能性について考え、研究・実験の基本的手法を学ぶ機会としました。
![]() |
![]() |
課研:テーマ設定~トライアル中間報告会~
12月2日(火)
ワークシートに書き込んだことを基に中間報告会を行いました。人に話すことで自分の中の考えを整理し、また、質疑応答で他の意見を取り入れたり考えを深めたりすることにより、テーマの方向性を明確にしていきました。今後は具体的な実験デザインを考えていきます。
![]() |
![]() |
課研:テーマ設定~ガイダンス・トライアル~
11月11日(火)
これまでに探究基礎講座(物理・化学・生物)を経験し、理数科3年次生と理数科2年次生の課題研究発表会の見学を終え、いよいよ自身の課題研究のテーマ設定に入りました。
「自分の興味関心を思考する」を目的に、テーマを決めるまでの7つのポイントを意識し、「好きなこと」「困っていること(とことん調べてみたいこと)」をワークシートに5つ書き出していきました。
【テーマを決めるまで】
① 自分自身の見聞・経験・観察・考えたことをもとに問題をみつける。
② 興味のあることや、面白いと思ったことを大切にする。
③ ゆっくりと、自分が気になる問題を自分の中で探す。
④ 最初からインターネット検索で問題やテーマの候補をみつけようとしない。(その後自分で考えようと思っても、見たテーマにとらわれてしまう。先に自分でまず考えることが大切)
⑤ 問題を「なぜ(Why)、○○は△△なのか?」か、「どのように(How)、○○は△△になっているのか?」という文に書く。
⑥ 書いてみた問題について、調査や実験を自分たちで始められそうかを検討する。
⑦ できれば、研究テーマの候補を3個〜10個用意する。
![]() |
![]() |
課研:SSH研究発表交流会~理数科の部 見学~
11月5日(水)
2年次生理数科の生徒が企画・運営・発表する課題研究発表会を見学しました。
第1部は物理・化学・生物の代表班によるステージ発表を見学しました。第2部は各教室で行われるブース発表を見学したり、展示室を訪れて実験器具やリサーチノート等を見学したりしました。
1年後の目指す姿を認識するとともに、これからのテーマ設定に向けて意欲がわき、向上心を持つきっかけとなりました。
![]() |
![]() |
課研:自由研究発表会
9月5日(金)
夏季休業中に身近な自然現象や科学技術に対する問いを見つけテーマ化し、テーマについて仮説を立て、これを検証する実験や観察を行いレポートにまとめました。
数人でグループになり、研究発表と質疑応答の時間を設け、相互評価をしました。
「自らの内にある「興味・関心・知的ときめき」を見つける」「実験や観察をデザインする力を養う」「実験や観察の方法を経験する」「論理的に考える力を養う」「実験を通して結果を検証する力を養う」「わかったことを他の人に伝える力を養う」ことを目的としています。
![]() |
![]() |
課研:城陵祭ポスター展示
8月30日(土),31日(日)
城陵祭文化の部の2日間に、夏季休業中に行った自由研究のレポートをサイエンスホールに展示しました。今後の授業でレポート発表会も行います。
2,3年次生の課題研究についての展示も併せて行いました。
![]() |
![]() |
SSR:サマーサイエンスセミナー
7月23日(水)~25(金)
滋賀県と福井県で2泊3日の研修を実施しました。「問い」を見つけ、研究のスキルを身に付けました。
1日目は滋賀県立琵琶湖博物館においてワークシートを記入しながらの展示見学、福井県年縞博物館で学芸員の方による講義と見学をしました。
2日目と3日目は、福井県海浜自然センターで「磯採集」「プランクトン観察」の実習、福井県立大学で「ウニの授精」「海藻の色素の分離」実験を行いました。
![]() |
![]() |
SSR:SSセミナー プレレクチャー
7月11日(金)
7月下旬に行われるサマーサイエンスセミナーの予習として、福井県立大学 海洋生物資源学部(小浜キャンパス)の佐藤晋也教授をお招きして「頑丈な藻類とその進化」という演題で講演をしていただきました。
珪藻にまつわる様々なお話や、藻類の形状について生物の進化と関連付けて、佐藤先生が研究されている「藻類」について熱く語ってくださいました。
![]() |
![]() |
課研:リサーチⅢ 課題発表発表会~見学~
7月3日(木)
理数科3年次生の発表会を見学しました。数学・物理・化学・生物の4分野27班が5会場に分かれて3年間の研究の成果を発表しました。
オンラインで5会場をつないだ合同開会式では、この発表会の意義について話がありました。
発表会後には3年次生と1年次生の交流の時間も設け、3年次生から1年次生に向けて、これまでの経験を踏まえて課題研究を行う上での考え方や取り組み方、実験のコツなどをアドバイスしました。
この発表会を見学し、2年後に目指す姿をイメージすることができました。
![]() |
![]() |
SSL:講義「論理的思考」
6月3日(火)
本校英語科の教諭による講義「論理的思考Ⅰ」を行ないました。論理的な言語と言われる英語による講義で、「三角ロジック」を用いて自分の意見を論理的に相手に伝える手法と、その重要性について学びました。例題に沿って英語で対話をするペアワークも取り入れた参加型の講義となりました。
![]() |
![]() |
課研:探究基礎講座~物理~
5月1日(木),5月20日(火),5月27日(火)
理数科1年次生78名を3つに分け、物理・化学・生物の各分野において実験を1週ごとに行い、研究の基礎となる実験技術や機器の操作、実験室の使い方やレポート作成の方法を学ぶ「探究基礎講座」を行いました。
>物理では「紙コップの不思議」を行いました。仮説を立てて実験し、得られた結果から考察を行う流れを繰り返し、レポートにまとめます。レポートにはテーマ:Title、目的:Purpose、仮説:Hypothesis、実験方法・使用器具:Experimental Design、結果:Results、考察・結論:Conclusion、活動の振り返り:Future Directionsの項目立てをし、評価ルーブリックによって一項目ごとに評価する手法までを身に付けます。
![]() |
![]() |
課研:探究基礎講座~化学~
5月1日(木),5月20日(火),5月27日(火)
化学では「科学のものの見方・捉え方を身に付けること」を目的とし、実験「カイロから塩を取り出す」を行いました。
仮説を立ててから実験を行い、現象をよく観察し、実験結果からその現象がなぜ起こるのか考えます。考えられる要因を挙げ、どの要因が強く影響するのか検証するための実験プランを班ごとに考え、発表し合います。その後、代表的な検証実験を行ってレポートにまとめます。
![]() |
![]() |
課研:探究基礎講座~生物~
5月1日(木),5月20日(火),5月27日(火)
生物では「ミクロの世界を見てみよう 顕微鏡の使い方」を行いました。
日常的に目にしているものをミクロの視点で見ることで、普段は何気なく見過ごしている生物や物質の不思議を実感することを目的としました。この実験を通して、日常生活や自然から問いを生み出す習慣を身に付けるとともに、視点を変えることによってものの見え方が変わってくるという気付きを得ることを学びます。
![]() |
![]() |
SSR:SSH開講記念講演会
5月13日(火)
本校同窓生である名古屋大学名誉教授の澤木宣彦先生による講演会を開催しました。
「半導体エレクトロニクス-夢を育む科学技術の研究-」という演題で、半導体エレクトロニクスの発展、エネルギー消費拡大と地球環境の変化、カーボンニュートラルについて、実物を提示しつつ生徒と対話しながらお話しくださいました。
先人の発明・発見の歴史をたどりながら、豊かな未来をつくるために私たちに何ができるか考える機会となりました。
![]() |
![]() |
課研:コラボレーションラボ~3年次課題研究の見学~
4月24日(木)
理数科3年次生の課題研究の授業を見学しました。
理数科1年次生の生徒78名を4つのグループに分け、数学・物理・化学・生物の各研究室を訪れました。訪問先では先輩にインタビューし、研究についての説明を受けました。課題研究の授業の様子を知り、自分の興味のある分野を考える機会となりました。
![]() |
![]() |
SSL:SSH期首ガイダンス
4月15日(火)
1年次生にとって初めてとなるSSHの授業は課題研究です。
まずはじめに論理的思考に関するアンケートを行い、その後ガイダンスを行ないました。これまでの恵那高校SSHにおける先輩の活動の様子から、「これからの時代に必要な能力は」「社会で必要な能力をいかに養成するか」「主体的なテーマ設定」「社会との共創」について知り、これから3年間で自分たちが目指す姿について確認しました。
ガイダンス終了後、課題研究や理数科における学びに向かう考え・意見・決意についてレポートにまとめました。